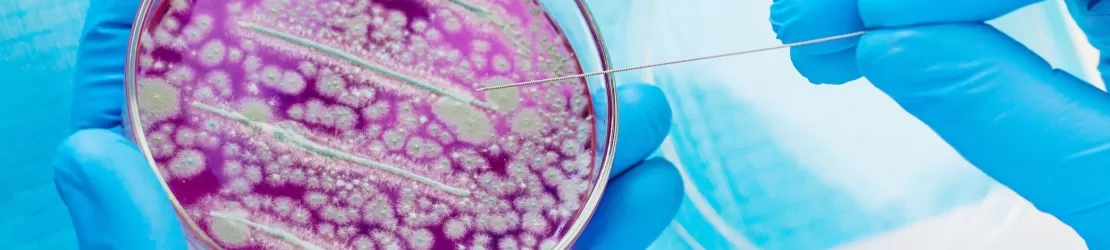
Cercetator examinand bacterii in placi Petri intr-un laborator, evidentiind studiul microbian si procedurile stiintifice pentru cercetare medicala si microbiologie.

Despre schistosomiază
Schistosomiaza este o boală parazitară cronică, cauzată de infecția cu viermi plați din genul Schistosoma. Este una dintre cele mai frecvente boli parazitare la nivel global, afectând în special populațiile din regiunile tropicale și subtropicale, unde accesul la apă potabilă sigură și la sisteme de canalizare este limitat.
Ciclul de viață al parazitului implică două gazde: omul și un melc de apă dulce. Larvele infecțioase, numite cercarii, pătrund prin piele în momentul contactului cu apa contaminată (înot, spălat, pescuit). După pătrundere, acestea migrează prin vasele de sânge, se maturizează și ajung în venele specifice organelor-țintă.
Viermii adulți depun ouă, o parte fiind eliminate prin urină sau scaun, iar altele rămân blocate în țesuturi. Reacția inflamatorie a organismului la ouăle reținute este responsabilă de majoritatea simptomelor și complicațiilor bolii, ducând la fibroză, leziuni tisulare și disfuncții organice.
În funcție de specia de Schistosoma și de organele afectate, există mai multe forme clinice:
- schistosomiaza intestinală (Schistosoma mansoni, S. japonicum): afectează intestinul și ficatul;
- schistosomiaza urogenitală (Schistosoma haematobium): afectează tractul urinar și organele genitale;
- forme mai rare cu afectare pulmonară sau neurologică.
Cauze
Cauza directă a schistosomiazei este infecția cu paraziți Schistosoma, dobândită prin expunerea la apă dulce infestată cu larvele acestora.
Principalele surse de infectare includ:
- lacuri, râuri, canale de irigații;
- ape stătătoare sau cu curgere lentă;
- zone cu populație mare de melci purtători.
Lipsa sistemelor sanitare adecvate permite eliminarea ouălor parazitului în mediul acvatic, perpetuând ciclul infecției.
Factori de risc
Riscul de a dezvolta schistosomiază este mai mare în următoarele situații:
- locuirea sau călătoria în zone endemice;
- contactul frecvent cu apă contaminată;
- activități precum pescuitul sau agricultura;
- copiii, care se joacă frecvent în apă;
- lipsa accesului la apă potabilă sigură;
- condiții precare de trai;
- prezența melcilor de apă dulce;
- lipsa educației sanitare.
Simptome
Simptomele schistosomiazei variază în funcție de stadiul bolii și de organul afectat. Mulți pacienți pot fi asimptomatici în fazele incipiente.
Simptomele precoce, din faza acută a bolii – cunoscută și sub numele de febră Katayama – includ:
- erupții cutanate și prurit la locul pătrunderii larvelor;
- febră;
- frisoane;
- dureri musculare;
- tuse seacă;
- oboseală accentuată.
Simptomele cronice diferă, în funcție de tipul bolii:
- schistosomiază intestinală;
- dureri abdominale;
- diaree cronică;
- sânge în scaun;
- pierdere în greutate;
- hipertensiune portală;
- hepatomegalie și splenomegalie;
- schistosomiază urogenitală;
- hematurie (sânge în urină);
- durere la urinare;
- infecții urinare recurente;
- fibroza vezicală;
- risc de cancer vezical;
- tulburări de fertilitate.
La copii, infecția cronică poate duce la anemie, afectare renală, afectare hepatica severa, malnutritie, întârziere în creștere și dezvoltare cognitivă deficitară.
Diagnosticare
Diagnosticul de schistosomiază este stabilit de un medic infecționist sau, uneori, de un medic gastroenterolog, ori urolog, în funcție de manifestări. Specialistul MedLife va recomanda o serie de investigații și analize:
- examinarea microscopică a scaunului sau urinei: pentru identificarea ouălor de Schistosoma;
- teste serologice: pentru detectarea anticorpilor specifici;
- analize de sânge: pentru eozinofilie, anemie;
- ecografie abdominală: pentru evaluarea ficatului, splinei și vezicii urinare;
- CT sau RMN: în cazurile complicate;
- biopsie: rar, pentru confirmarea bolii.
Diagnosticul precoce este esențial pentru prevenirea complicațiilor ireversibile.
Tratament
Tratamentul schistosomiazei este eficient, mai ales în stadiile incipiente:
- tratamentul cauzei: obiectivul principal îl reprezintă eliminarea parazitului; tratamentul antiparazitar distruge viermii adulți, reducând inflamația și prevenind depunerea de noi ouă;
- medicamente: medicamentul indicat (praziquantel, de primă linie) este eficient împotriva tuturor speciilor de Schistosoma; uneori, tratamentul se repetă după câteva săptămâni. În formele severe, specialistul MedLife poate recomanda și medicamente antiinflamatoare sau corticosteroizi;
- modificări ale stilului de viață: presupun:
- evitarea contactului cu ape dulci nesigure;
- respectarea măsurilor de igienă;
- utilizarea apei potabile tratate;
- respectarea controalelor medicale periodice;
- educația sanitară.
Complicații
În lipsa tratamentului, schistosomiaza poate duce la complicații grave:
- fibroză hepatică și hipertensiune portală;
- insuficiență renală;
- leziuni permanente ale vezicii urinare;
- creșterea riscului de cancer de vezică urinară;
- infertilitate;
- afectare neurologică (convulsii, paralizii).
Prevenție
Prevenția schistosomiazei se bazează pe:
- evitarea înotului în ape dulci din zone endemice;
- utilizarea apei îmbuteliate sau tratate;
- îmbunătățirea sistemelor de canalizare;
- tratamentul în masă al populațiilor expuse;
- educația sanitară;
- screeningul medical pentru persoanele expuse.
Întrebări frecvente despre schistosomiază
Ce este schistosomiaza și ce cauze o pot declanșa?
Care sunt simptomele frecvente ale schistosomiazei?
Este frecventă schistosomiaza în România?
Este contagioasă schistosomiaza?
Bibliografie
- World. “Schistosomiasis.”Who.int, World Health Organization: WHO, Feb. 2023, www.who.int/news-room/fact-sheets/detail/schistosomiasis. Accessed 17 Jan. 2026.
- “Schistosomiasis: Transmission, Symptoms & Treatment.”Cleveland Clinic, Apr. 2022, my.clevelandclinic.org/health/diseases/22631-schistosomiasis. Accessed 17 Jan. 2026.
- MD, Ahmed,. “Schistosomiasis (Bilharzia): Background, Pathophysiology, Etiology.”Medscape.com, Medscape, 29 Oct. 2024, emedicine.medscape.com/article/228392-overview?form=fpf. Accessed 17 Jan. 2026.
- “Schistosomiasis.”Patient.info, 2023, patient.info/doctor/infectious-disease/schistosomiasis-pro. Accessed 17 Jan. 2026.
- “Schistosomiasis: MedlinePlus Medical Encyclopedia.”Medlineplus.gov, 2020, medlineplus.gov/ency/article/001321.htm. Accessed 17 Jan. 2026.
- CDC. “Schistosomiasis.”Yellow Book, 8 July 2025, www.cdc.gov/yellow-book/hcp/travel-associated-infections-diseases/schistosomiasis.html. Accessed 17 Jan. 2026.
Solicită o programare
Alege opțiunea de a te programa online, simplu și rapid, prin intermediul formularului de programare.